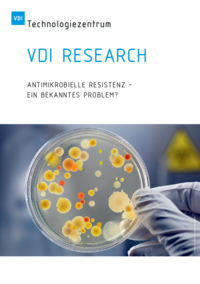

VDI Research
Antimikrobielle Resistenz - ein bekanntes Problem?
Eine neues Paper von VDI Research widmet sich der Antimikrobiellen Resistenz.
Neue Herausforderungen im Kampf gegen Resistenzen
Bakterien, Parasiten, Pilze und Viren können sich derart verändern, dass sie auf eine Behandlung mit verfügbaren Arzneimitteln nicht mehr ansprechen. Antimikrobielle Resistenz (AMR) tritt auf, wenn diese Mikroorganismen eine Unempfindlichkeit gegen die Wirkung von antimikrobiellen Arzneimitteln entwickelt haben. Neben Resistenzen gegen einzelne Wirkstoffe sind insbesondere Multiresistenzen problematisch, da die Erreger hier gegen gleich mehrere Wirkstoffe unempfindlich geworden sind. Im schlimmsten Fall droht die Panresistenz – eine Resistenz gegen alle verfügbaren Wirkstoffe. AMR entwickelt sich zu einer gesellschaftlichen Bedrohung. Die Zunahme resistenter Mikroorganismen führt zu schwer therapierbaren Erkrankungen und zahlreichen Todesfällen. Als Hauptursache für die Entstehung von AMR gilt der inflationäre und unsachgemäße Gebrauch von Arzneimitteln wie Antibiotika, Virostatika oder Antimykotika.
Als besonders kritisch ist die Zunahme bakterieller Infektionen einzustufen, bei denen verfügbare Antibiotika keine Wirkung mehr zeigen. In diesem Zusammenhang sind insbesondere multiresistente bakterielle Erreger, die sich vor allem in Krankenhäusern verbreiten und dort zu schweren Erkrankungen der Patienten führen können, zu nennen. Der bekannteste Vertreter dieser Erreger ist der gegen Methicillin resistente Staphylococcus aureus (MRSA). Staphylokokken sind weit verbreitete Bakterien und besiedeln insbesondere die Haut an Achseln und Leisten sowie die Schleimhäute im Nasenrachenraum. Normalerweise führt die Besiedlung mit MRSA nicht zu Erkrankungen. Gelangen die Bakterien jedoch über Wunden in den Körper, kann dies zu Infektionen führen. Problematisch ist, dass MRSA-Stämme gegen die meisten relevanten Antibiotikaklassen resistent sind. Dadurch können die Infektionen einen schweren Verlauf nehmen, der nicht selten zum Tod führt.
Die Zahlen zu Antibiotikaresistenzen sind alarmierend. Einer aktuellen Studie zufolge starben im Jahr 2019 weltweit mehr als 1,2 Millionen Menschen an einer Infektion mit einem antibiotikaresistenten Erreger1. Demnach gehören derartige Infektionen zu den häufigsten Todesursachen. Allein MRSA war nach den Berechnungen für mehr als 100.000 Todesfälle verantwortlich. Diese Entwicklung stellt den Gesundheitssektor vor große Herausforderungen. Bereits im Jahr 2019 warnte die Weltgesundheitsorganisation (WHO), dass Antibiotikaresistenzen weltweit alarmierende Ausmaße annehmen. WHO-Generaldirektor Tedros Adhanom Ghebreyesus betonte, dass „die Antibiotikaresistenz droht, 100 Jahre medizinischen Fortschritts zunichtezumachen“.2 Die WHO hat eine neue Einteilung der vorhandenen Antibiotika in drei Kategorien mit entsprechenden Empfehlungen zum gezielteren Einsatz der Mittel vorgenommen.3 Neben der WHO stellen sich zahlreiche weitere Organisationen und Initiativen auf nationaler sowie inter- und supranationaler Ebene der Herausforderung im Kampf gegen multiresistente Erreger und treiben Initiativen und Aktivitäten voran. So wurden auch in Deutschland zahlreiche gesundheitspolitische Maßnahmen eingeleitet, um der Herausforderung zu begegnen. Das Bundesministerium für Gesundheit (BMG), das Bundesministerium für Ernährung und Landwirtschaft (BMEL) sowie das Bundesministerium für Bildung und Forschung (BMBF) haben im Jahr 2015 die Deutsche Antibiotika-Resistenzstrategie (DART 2020) initiiert. Sie thematisiert sowohl die Antibiotika-Resistenzbekämpfung bei Menschen als auch bei Tieren. Im kürzlich erschienenen Abschlussbericht4 zu DART 2020 werden zwar erste Erfolge im Kampf gegen Antibiotikaresistenzen dokumentiert, auf die Notwendigkeit zur Durchführung weiterer Maßnahmen wird jedoch deutlich hingewiesen. Notwendige Anpassungen werden weiterhin insbesondere bei dem sachgemäßen Einsatz von Antibiotika in der Human- und Veterinärmedizin gesehen. Eine Nachfolgestrategie wurde bereits auf den Weg gebracht: DART 2030 soll sich bis zum Jahr 2030 der Herausforderung unter verstärkter Berücksichtigung des „One Health“-Ansatzes5 widmen.
Es existieren bereits zahlreiche Herangehensweisen und Lösungsansätze, um der Bedrohung durch multiresistente Erreger zu begegnen. Hierzu zählen in erster Linie Maßnahmen zur Prävention, wie die Verhinderung der Ausbreitung der resistenten Erreger durch verbesserte Hygienestandards in Gesundheitseinrichtungen, Weiterbildungsmaßnahmen für medizinisches Personal, Meldepflichten, Isolationsanordnungen etc. In die Reihe der Präventionsmaßnahmen ordnen sich auch technologische Innovationen ein. So sind erste Desinfektionsroboter auf dem Markt, die mittels UV-C-Licht6 Keime wie MRSA und andere problematische Erreger beseitigen. Die mit UV-C-Röhren ausgestatteten Roboter werden in Krankenhäusern eingesetzt und befreien dort Räume selbstständig von Keimen.7
Da im Fall von Antibiotikaresistenzen neben dem übermäßigen oder unsachgemäßen Gebrauch von Antibiotika in der Humanmedizin auch deren Einsatz in der (Massen-)Tierhaltung als relevante Ursache für die Zunahme der Resistenzen gilt, zielen verbesserte hygienische Maßnahmen auch auf diesen Bereich. In der Tiermedizin findet ein breites Spektrum an Antibiotika Anwendung. Zwar konnte in Deutschland der jährliche Verbrauch von Antibiotikawirkstoffen in der Tiermedizin zwischen 2011 und 2018 von 1.706 Tonnen auf 722 Tonnen reduziert werden8, zur Bekämpfung der Resistenzen sind hier jedoch weiterführende Maßnahmen erforderlich. Beispiele hierfür sind die Verpflichtung zur Erstellung von Antibiogrammen9, die vorbeugende Impfung gegen regelmäßig auftretende Infektionen – auch mit individuell hergestellten, bestandsspezifischen Impfstoffen für einzelne Tierbestände – sowie präventive Hygienemaßnahmen.10
Ansatzpunkte zur Bekämpfung von Antibiotikaresistenzen – sowohl in präventiver als auch therapeutischer Hinsicht – finden sich auch in der Pharmaforschung. Neben der Entwicklung neuer Antibiotika ist hier beispielsweise die Suche nach Impfstoffen gegen antibiotikaresistente Bakterien zu nennen. Die Entwicklung von Impfstoffen gegen Bakterien ist sehr komplex und bislang nicht von Erfolg gekrönt. Nachdem Projekte scheiterten, die sich auf die Oberflächen von Bakterien oder gegen die von ihnen gebildeten Toxine gerichtet haben, zielt ein neuer, vielversprechender Ansatz auf den Stoffwechsel der Bakterien.11 Pharmaunternehmen sind jedoch kaum noch bereit, in die Entwicklung neuer Antibiotika zu investieren. Dieser Geschäftsbereich gilt als wenig lukrativ. Die Kosten für die Entwicklung von Antibiotika wie auch von Impfstoffen gegen resistente Bakterien sind hoch, die Erfolgsraten gering. Zudem können Bakterien schnell neue Resistenzen gegen neue Antibiotika entwickeln. Ein Lösungsansatz, um die Kosten für die Wirkstoffforschung zu reduzieren, kann im „Genom-Mining“ gesehen werden. Bei diesem Verfahren kommen Algorithmen der Bioinformatik zum Einsatz, um neue Antibiotika zu identifizieren. Die Algorithmen prognostizieren, wie ein erfolgreicher Wirkstoff am wahrscheinlichsten aussieht und wie er zusammengesetzt ist. Der Wirkstoff kann anschließend künstlich synthetisiert werden. Die teuren und aufwendigen Vorarbeiten im Labor entfallen hierbei. Auf diese Weise entstanden in den vergangenen Monaten zwei neue Antibiotika, die auch gegen MRSA wirksam sind.12
Auch der Einsatz von Bakteriophagen gilt als Option für die Therapie, wie auch die Prävention von Erkrankungen mit resistenten Bakterien. Bakteriophagen sind Viren, die Bakterien infizieren. Ihr Wirkspektrum ist jeweils sehr eng auf bestimmte Bakterienstämme begrenzt. Dies hat den Vorteil, dass bakterielle Infektionen sehr spezifisch bekämpft werden können und weniger Nebenwirkungen in Kauf genommen werden müssen. Gegenüber Antibiotika besteht zudem der Vorteil, dass gegen Bakteriophagen gebildete Resistenzen für den Menschen ungefährlich sind. Die Phagentherapie im Sinne einer therapeutischen Nutzung von Bakteriophagen zur Behandlung bakterieller Infektionen ist nicht neu. Insbesondere in Osteuropa wird diese Therapieform seit Jahrzehnten angewendet. Im Zusammenhang mit der Bekämpfung von Antibiotikaresistenzen ist dieser Ansatz nun wieder in den Fokus gerückt. Auch in Deutschland werden entsprechende Forschungsvorhaben gefördert und könnten diese Therapieoption nutzbar machen.13 Auch in der Tiermedizin wird die Phagentherapie als Ansatzpunkt im Kampf gegen Antibiotikaresistenzen diskutiert.14
Antibiotikaresistenzen sind jedoch nur eine der zu bewältigenden Herausforderungen im Zusammenhang mit AMR. Während die Gefahr durch multiresistente Bakterien in der Öffentlichkeit weitestgehend präsent ist, stellen (multi-)resistente Pilze eine relativ neue und weniger bekannte Herausforderung dar. Im Jahr 2009 wurde in Japan erstmals der Pilz „Candida auris“ beschrieben15. Der Erreger verursacht in der Regel harmlose Ohrenentzündungen, kann aber auch andere Bereiche des Körpers befallen. Candida auris ist von Mensch zu Mensch übertragbar und gegen wichtige Antimykotika resistent. Problematisch und potenziell lebensbedrohlich ist dies insbesondere für immungeschwächte Menschen. Inzwischen hat sich der Pilz in weiteren Ländern ausgebreitet und zu Wundinfektionen, Blutvergiftungen und in deren Konsequenz zu Todesfällen geführt. Es wurden bereits mehrere Ausbrüche in Krankenhäusern dokumentiert.16 Im vergangenen Jahr berichtete die US-amerikanische Gesundheitsbehörde CDC (Centers for Disease Control and Prevention, englisch für Zentren für Krankheitskontrolle und -prävention) über Ausbrüche von Candida-auris-Infektionen in Pflegeeinrichtungen, bei denen Fälle von Panresistenz auftraten und demnach sämtliche Antimykotika wirkungslos waren.17 Auch im Zusammenhang mit der COVID-19-Pandemie wurde von Ausbrüchen in verschiedenen Ländern berichtet.18 Als mögliche Ursachen hierfür werden diskutiert: die hohe Belegung in den Krankenhäusern, Personalmangel auf den Stationen, Lieferengpässe bei notwendigen Produkten wie Schutzkleidung und Desinfektionsmitteln, aber auch der schlechte Gesundheitszustand der durch das Coronavirus geschwächten Patienten. Resistente Pilze wie Candida auris haben das Potenzial, zu einer großen therapeutischen Herausforderung zu werden. Durch die COVID-19-Pandemie wurde dieser Umstand ein kleines Stück weiter in das Bewusstsein gerückt.
Fazit
Antimikrobielle Resistenz stellt eine der großen Bedrohungen für die Zukunft dar. Die Gefahren durch multiresistente Bakterien sind mittlerweile überwiegend erkannt, entsprechende Initiativen und Maßnahmen wurden eingeleitet und müssen kontinuierlich angepasst werden. Aus der Forschung gibt es vielversprechende Ansätze. Ein grundsätzlicher Durchbruch zur Lösung des Problems ist jedoch gegenwärtig nicht in Sicht. Daher bedarf es weiterer Forschung nach innovativen Ansatzpunkten und entsprechender Förderinstrumente. In Bezug auf multiresistente Pilze muss das Bewusstsein für die möglichen Konsequenzen noch geschaffen werden. Andernfalls kann hier eine größer werdende Herausforderung erwachsen, die für das Gesundheitssystem zu erheblichen Mehrbelastungen führt. Vergrößertes Bewusstsein ist Voraussetzung dafür, ein Nachlassen ökonomischer und forschungsmittelbezogener Anstrengungen gegen fortschreitende Resistenzen zu vermeiden.15
Ihre Ansprechpersonen
VDI Research
Prof. Dr. Dr. Axel Zweck
Eva Cebulla
E-Mail: cebulla@vdi.de
Quellen und weiterführende Links
- Antimicrobial Resistance Collaborators (2022): Global burden of bacterial antimicrobial resistance in 2019: a systematic analysis. In: Lancet 2022; 399: 629–655.
- WHO stuft Antibiotika wegen Resistenzen neu ein: https://www.aerzteblatt.de/nachrichten/104002/WHO-stuft-Antibiotika-wegen-Resistenzen-neu-ein, zuletzt geprüft am 19.01.2023.
- ebenda.
- Bundesministerium für Gesundheit (Hrsg.) (2022): DART 2020 – Abschlussbericht. https://www.bundesgesundheitsministerium.de/fileadmin/Dateien/3_Downloads/D/DART_2020/BMG_DART_2020_Abschlussbericht_bf.pdf, zuletzt geprüft am 19.01.2023.
- Der „One Health“ Ansatz berücksichtigt, dass die Gesundheit von Mensch, Tier und Umwelt eng miteinander verknüpft sind. Gemäß diesem Ansatz sollen Akteure aus verschiedenen Disziplinen (Humanmedizin, Veterinärmedizin, Umweltwissenschaften) fächerübergreifend zusammenarbeiten.
- UV-C bezeichnet Ultraviolettstrahlung (UV) mit einer Wellenlänge von 280 bis 100 Nanometern (nm).
- Sieben, P. (2020): „Schleichende Pandemie“ abseits von Corona: Roboter bekämpft gefährliche Keime: https://www.ingenieur.de/technik/fachbereiche/robotik/schleichende-pandemie-abseits-von-corona-roboter-bekaempft-gefaehrliche-keime/, zuletzt geprüft am 19.01.2023.
- Verein Deutscher Ingenieure (2020): Lebensretter Antibiotika - Kampf gegen Resistenzen und Entwicklung neuer Wirkstoffe, S. 12.
- Ein Antibiogramm ist das Ergebnis einer mikrobiologischen Untersuchung zur Bestimmung der Empfindlichkeit bzw. Resistenz von mikrobiellen Krankheitserregern gegenüber Antibiotika.
- Verein Deutscher Ingenieure (2020): Lebensretter Antibiotika - Kampf gegen Resistenzen und Entwicklung neuer Wirkstoffe, S. 12-13.
- Schilling, Jo (2022): Der Nächste, bitte! In: Technology Review, 1/2022, S. 50-55.
- Benz, A. (2022): Neue Antibiotika gegen resistente Keime. https://www.spektrum.de/news/neue-antibiotika-gegen-resistente-keime/2024524, zuletzt geprüft am 19.01.2023.
- Z. B. Phage4Cure - Entwicklung von Bakteriophagen als zugelassenes Medikament gegen bakterielle Infektionen: https://phage4cure.de/; PhagoFlow: Praktikabilitätstestung der magistralen Herstellung von Bakteriophagen zur Therapie septischer Infektionen an der unteren Extremität: https://www.phagoflow.de/detaillierte-projektbeschreibung/, zuletzt geprüft am 19.01.2023.
- Verein Deutscher Ingenieure (2020): Lebensretter Antibiotika - Kampf gegen Resistenzen und Entwicklung neuer Wirkstoffe, S. 12-13
- Candida auris: Steckbrief eines neuen Pilzes: https://www.aerzteblatt.de/archiv/208970/Candida-auris-Steckbrief-eines-neuen-Pilzes, zuletzt geprüft am 19.01.2023.
- Robert Koch Institut (2017): Erhöhte Aufmerksamkeit bei Candida-auris-Fällen notwendig. Epidemiologisches Bulletin 36/2017, S. 414.
- Centers for Disease Control and Prevention (2021): Transmission of Pan-Resistant and Echinocandin-Resistant Candida auris in Health Care Facilities ― Texas and the District of Columbia, January–April 2021 (Notes from the Field). Morbidity and Mortality Weekly Report (MMWR), Weekly / July 23, 2021 / 70(29);1022–1023.
- McKenna, M. (2021): Mykosen - Verkannte Gesundheitsgefahr. Spektrum der Wissenschaft, 8/21, S. 42 ff.; European Centre for Disease Prevention and Control (2022): Candida auris outbreak in healthcare in northern Italy, 2019-2021. ECDC: Stockholm: https://www.ecdc.europa.eu/sites/default/files/documents/RRA-candida-auris-Feb2022.pdf, zuletzt geprüft am 19.01.2023.

VDI Research
Antimikrobielle Resistenz - ein bekanntes Problem?
Eine neues Paper von VDI Research widmet sich der Antimikrobiellen Resistenz.